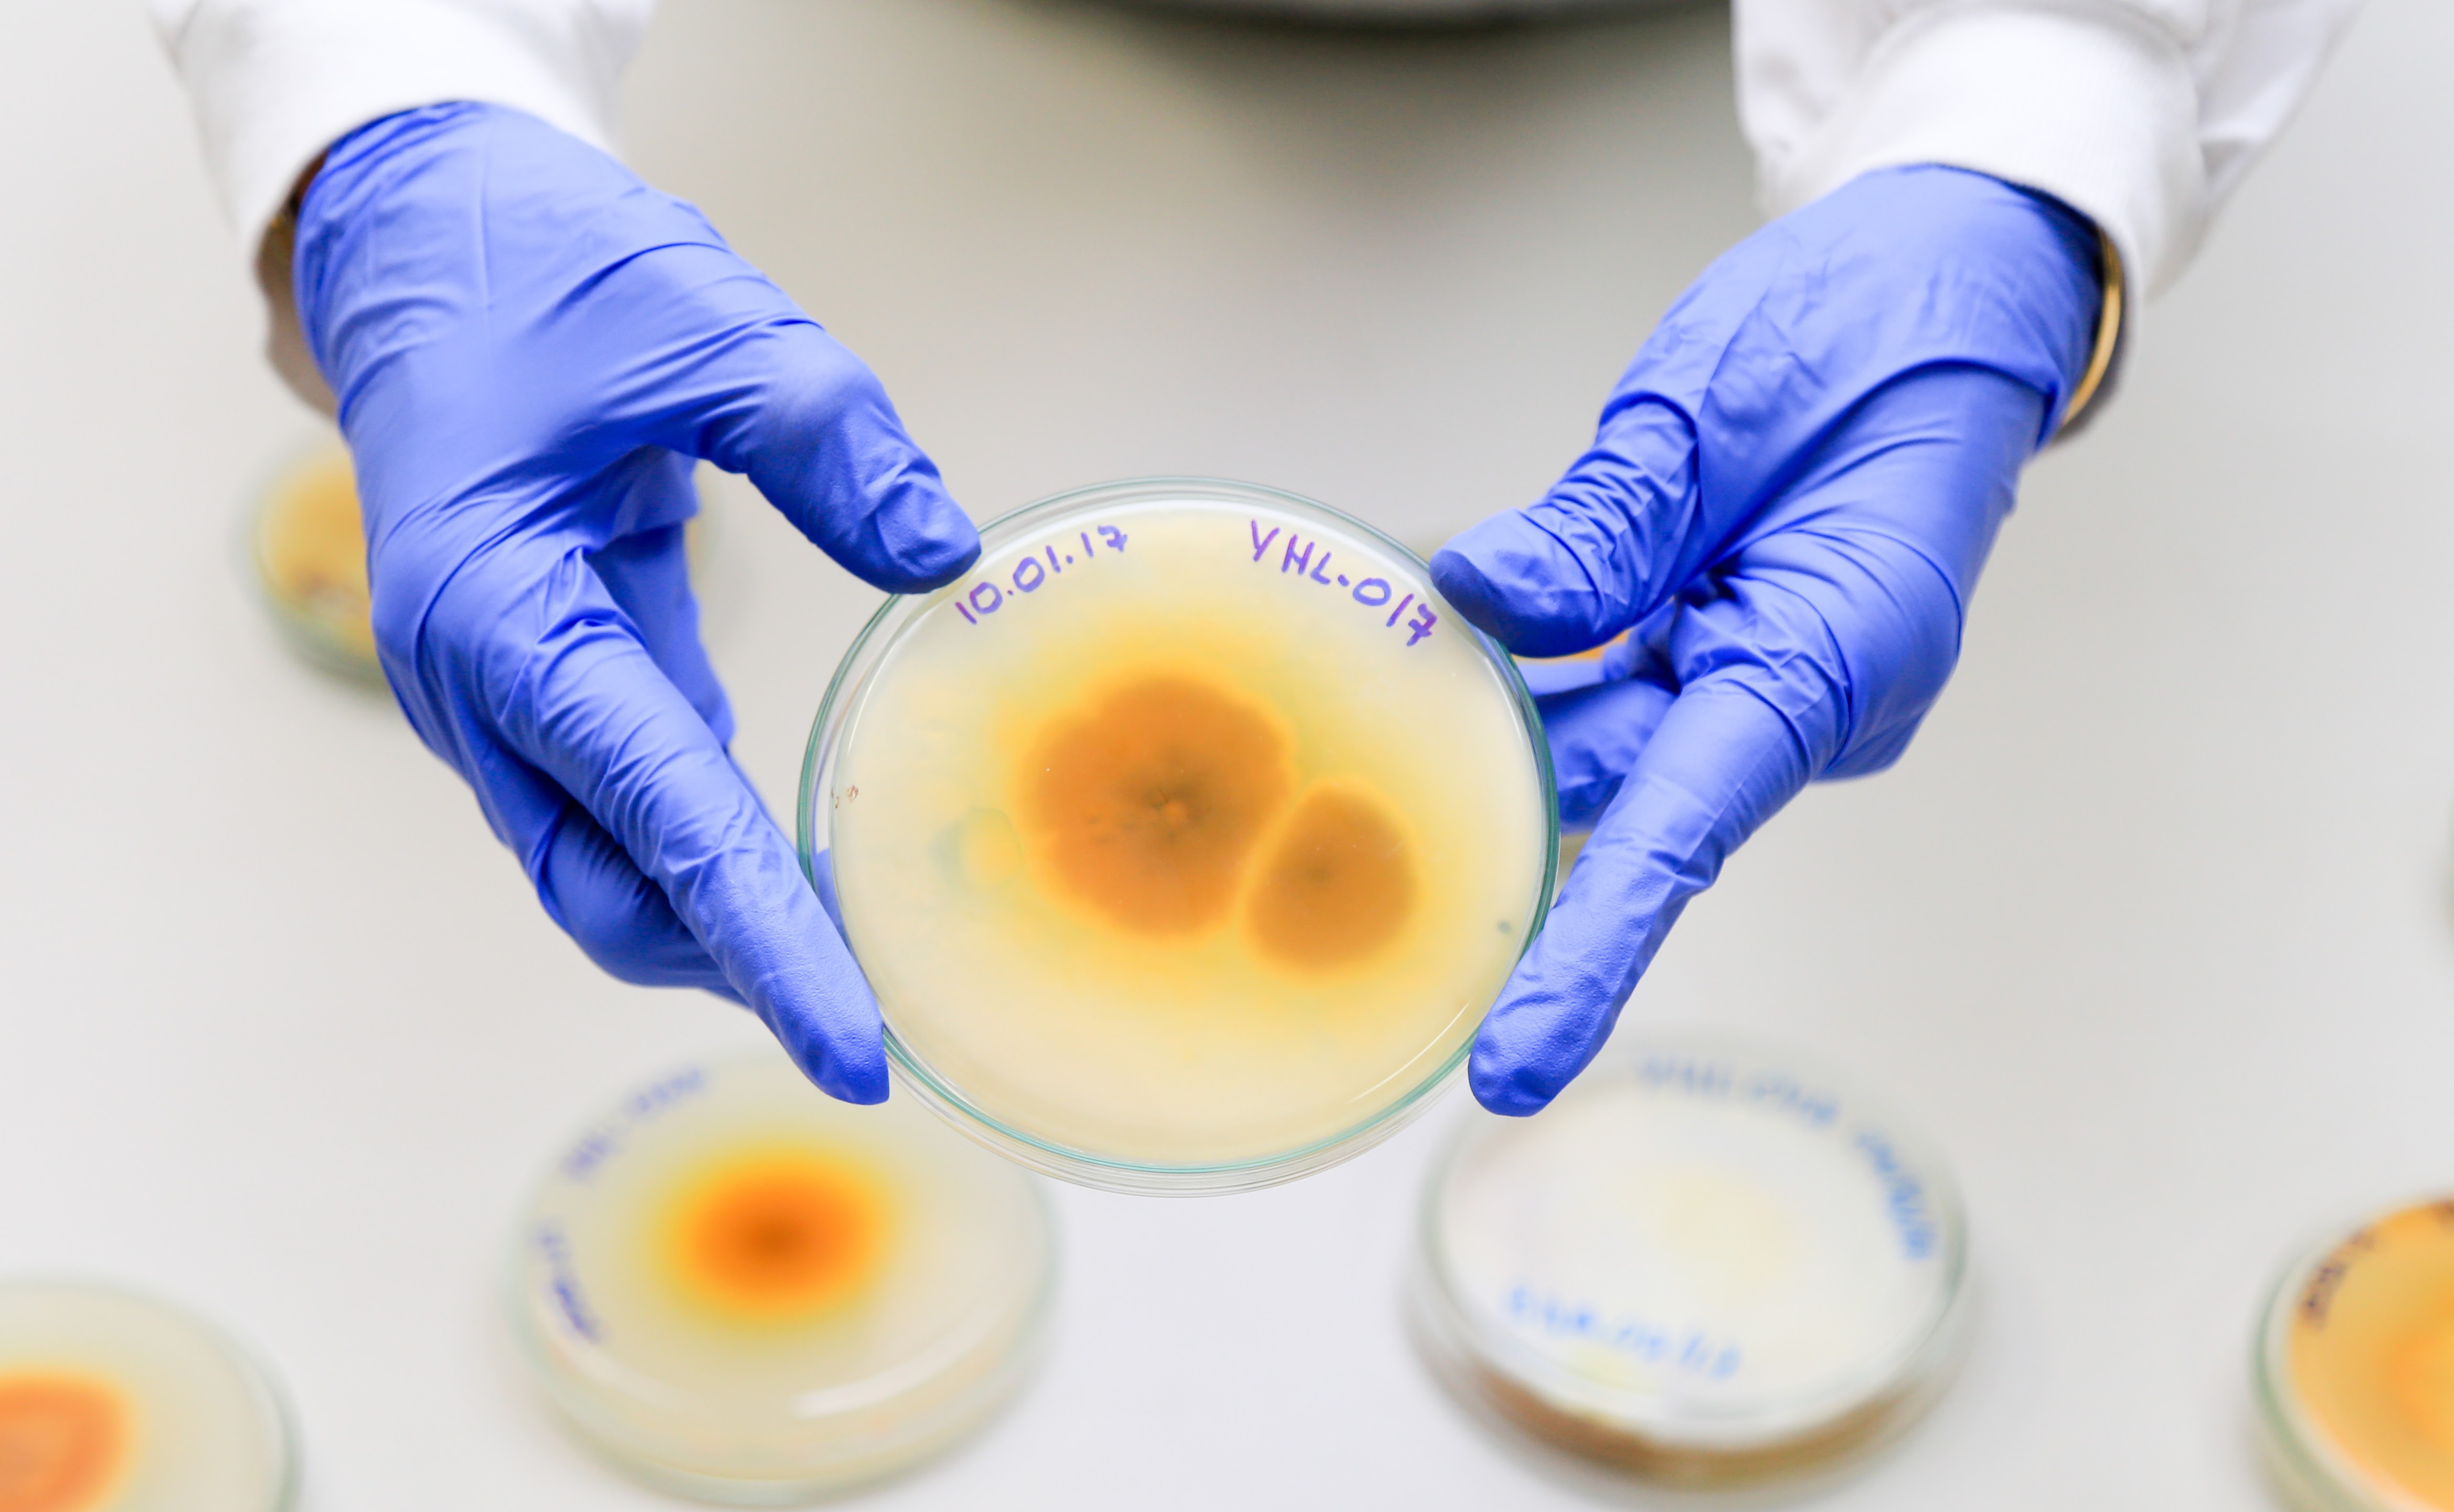
Fungos presente na Amazônia podem combater Aedes Aegypti

Pesquisadores analisam fungos encontrados em solos da Amazônia com o potencial para auxiliar no combate de ovos e larvas do Aedes aegypti, mosquito transmissor da dengue, zika vírus e chikungunya.
A pesquisa está sendo desenvolvida no âmbito do Programa de Apoio à Fixação de Doutores no Amazonas (Fixam-AM) da Fapeam, e será testada nas cidades de Manaus e Presidente Figueiredo.
O estudo realizado no laboratório de microbiologia da Universidade do Estado do Amazonas (UEA) iniciou em 2016 e tem previsão de conclusão em 2018. Até o momento, já foi já feito o isolamento de 10 linhagens de espécies fúngicas encontrados nos solos de Manaus e do município de Presidente Figueiredo.
Testes
De acordo com a coordenadora do estudo, a bióloga Yamile Benaion Alencar, as linhagens selecionadas irão passar por testes, que indicarão a potencialidade de cada em causar a mortalidade do Aedes aegypti. Os experimentos serão realizados no laboratório de Malária e Dengue do Instituto Nacional de Pesquisas da Amazônia (Inpa).
“Pretendemos fazer a identificação molecular dos fungos isolados e dos que apresentarem atividade inseticida. Com isso, poderemos determinar se o mesmo está na lista dos fungos permitidos para comercialização pelo Ministério da Agricultura, ou seja, não nocivos aos seres humanos e outros animais, mas com ação entomopatogênica para ovos, larvas e adultos do Aedes aegypti”, contou a pesquisadora.
Com os resultados obtidos a equipe pretende ter um produto de ação inseticida de fácil manejo, inofensivo ao homem, disponívelno mercado regional, e até mesmo nacional, evitando o uso de produtos químicos no ambiente e colaborando para o manejo correto do inseto, sem prejudicar a saúde da população humana.
Fungos Entomopatogênicos
Doutora em Ciências Biológicas, Yamile Benaion Alencar, explicou que os fungos entomopatogênicos podem parasitar insetos, matando ou os incapacitando e não causam nenhum malefício ao homem.
Segundo Yamile, o grupo de pesquisa já atua há alguns anos na Amazônia direcionando pesquisas para encontrar um microrganismo, no caso os fungos, de ação contra os insetos.
“São fungos já conhecidos, que ocorrem naturalmente, não causam nenhum problema para a saúde do homem. Algumas espécies já são até usadas para combater pragas na agricultura. Continuamos em busca de espécies de fungos que tenham ação eficaz contra o mosquito” explicou Yamile.
A pesquisadora contou que após a identificação do fungo com ação no combate aos ovos e larvas do mosquito será feita a análise dos compostos químicos em colaboração com o pesquisador doutor Hector Koolen do |Laboratório de Química Estrutural da Escola Superior em Ciências da Saúde da UEA (ESA/ UEA).
Sobre FIXAM-AM
O Programa de Apoio à Fixação de Doutores no Amazonas (Fixam-AM) da Fapeam estimula a fixação de recursos humanos com experiência em ciência, tecnologia e inovação e/ou reconhecida competência profissional em instituições de ensino superior e pesquisa, institutos de pesquisa, empresas públicas de pesquisa e desenvolvimento, empresas privadas e microempresas que atuem em investigação científica ou tecnológica.

Aviso